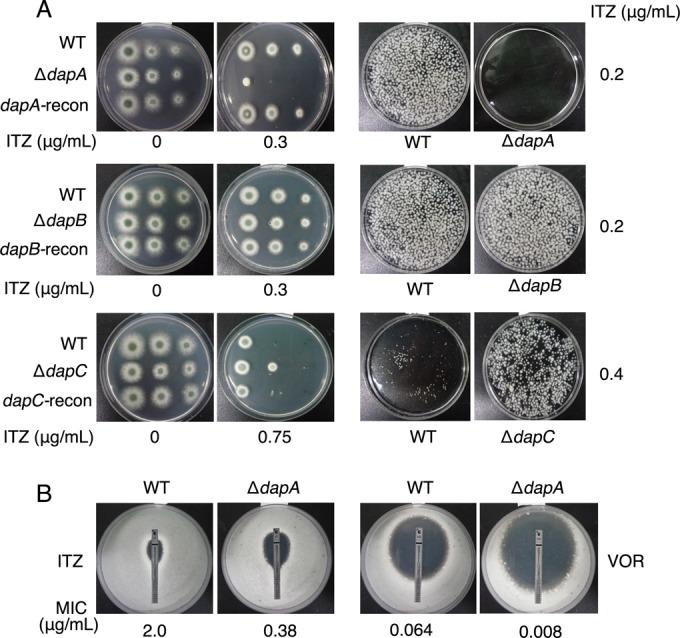
https://cdn.ncbi.nlm.nih.gov/pmc/blobs/f49b/4791848/64de087535cd/mbo0011626850002.jpg
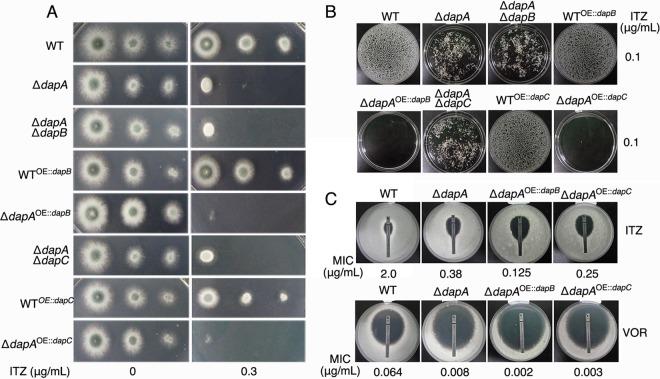
https://cdn.ncbi.nlm.nih.gov/pmc/blobs/f49b/4791848/d1bc4919558f/mbo0011626850003.jpg

烟曲霉抗损伤蛋白家族协同调节麦角固醇生物合成及唑类药物敏感性。
The Aspergillus fumigatus Damage Resistance Protein Family Coordinately Regulates Ergosterol Biosynthesis and Azole Susceptibility.
作者信息
Song Jinxing, Zhai Pengfei, Zhang Yuanwei, Zhang Caiyun, Sang Hong, Han Guanzhu, Keller Nancy P, Lu Ling
机构信息
Jiangsu Key Laboratory for Microbes and Functional Genomics, Jiangsu Engineering and Technology Research Center for Microbiology, College of Life Sciences, Nanjing Normal University, Nanjing, China.
Department of Dermatology, Jinling Hospital, School of Medicine, Nanjing University, Nanjing, China.
出版信息
mBio. 2016 Feb 23;7(1):e01919-15. doi: 10.1128/mBio.01919-15.
UNLABELLED
Ergosterol is a major and specific component of the fungal plasma membrane, and thus, the cytochrome P450 enzymes (Erg proteins) that catalyze ergosterol synthesis have been selected as valuable targets of azole antifungals. However, the opportunistic pathogen Aspergillus fumigatus has developed worldwide resistance to azoles largely through mutations in the cytochrome P450 enzyme Cyp51 (Erg11). In this study, we demonstrate that a cytochrome b5-like heme-binding damage resistance protein (Dap) family, comprised of DapA, DapB, and DapC, coordinately regulates the functionality of cytochrome P450 enzymes Erg5 and Erg11 and oppositely affects susceptibility to azoles. The expression of all three genes is induced in an azole concentration-dependent way, and the decreased susceptibility to azoles requires DapA stabilization of cytochrome P450 protein activity. In contrast, overexpression of DapB and DapC causes dysfunction of Erg5 and Erg11, resulting in abnormal accumulation of sterol intermediates and further accentuating the sensitivity of ΔdapA strains to azoles. The results of exogenous-hemin rescue and heme-binding-site mutagenesis experiments demonstrate that the heme binding of DapA contributes the decreased azole susceptibility, while DapB and -C are capable of reducing the activities of Erg5 and Erg11 through depletion of heme. In vivo data demonstrate that inactivated DapA combined with activated DapB yields an A. fumigatus mutant that is easily treatable with azoles in an immunocompromised mouse model of invasive pulmonary aspergillosis. Compared to the single Dap proteins found in Saccharomyces cerevisiae and Schizosaccharomyces pombe, we suggest that this complex Dap family regulatory system emerged during the evolution of fungi as an adaptive means to regulate ergosterol synthesis in response to environmental stimuli.
IMPORTANCE
Knowledge of the ergosterol biosynthesis route in fungal pathogens is useful in the design of new antifungal drugs and could aid in the study of antifungal-drug resistance mechanisms. In this study, we demonstrate that three cytochrome b5-like Dap proteins coordinately regulate the azole resistance and ergosterol biosynthesis catalyzed by cytochrome P450 proteins. Our new insights into the Dap regulatory system in fungal pathogens may have broad therapeutic ramifications beyond their usefulness for classic azole antifungals. Moreover, our elucidation of the molecular mechanism of Dap regulation of cytochrome P450 protein functionality through heme-binding activity may extend beyond the Kingdom Fungi with applicability toward Dap protein regulation of mammalian sterol synthesis.
未标记
麦角固醇是真菌质膜的主要且特定的成分,因此,催化麦角固醇合成的细胞色素P450酶(Erg蛋白)已被选为唑类抗真菌药的重要作用靶点。然而,机会性致病真菌烟曲霉已在全球范围内对唑类产生耐药性,主要是通过细胞色素P450酶Cyp51(Erg11)的突变。在本研究中,我们证明了由DapA、DapB和DapC组成的细胞色素b5样血红素结合损伤抗性蛋白(Dap)家族协同调节细胞色素P450酶Erg5和Erg11的功能,并相反地影响对唑类的敏感性。所有这三个基因的表达均以唑类浓度依赖性方式被诱导,对唑类敏感性的降低需要DapA稳定细胞色素P450蛋白的活性。相反,DapB和DapC的过表达导致Erg5和Erg11功能失调,导致甾醇中间体异常积累,并进一步加剧ΔdapA菌株对唑类的敏感性。外源血红素拯救和血红素结合位点诱变实验结果表明,DapA的血红素结合导致唑类敏感性降低,而DapB和DapC能够通过血红素耗竭降低Erg5和Erg11的活性。体内数据表明,失活的DapA与激活的DapB结合产生的烟曲霉突变体,在侵袭性肺曲霉病免疫受损小鼠模型中很容易用唑类治疗。与酿酒酵母和粟酒裂殖酵母中发现的单一Dap蛋白相比,我们认为这种复杂的Dap家族调节系统在真菌进化过程中出现,作为一种适应性手段,以响应环境刺激调节麦角固醇合成。
重要性
了解真菌病原体中麦角固醇生物合成途径有助于设计新的抗真菌药物,并有助于研究抗真菌药物耐药机制。在本研究中,我们证明了三种细胞色素b5样Dap蛋白协同调节细胞色素P450蛋白催化的唑类抗性和麦角固醇生物合成。我们对真菌病原体中Dap调节系统的新见解可能具有广泛的治疗意义,而不仅仅局限于对经典唑类抗真菌药的作用。此外,我们对Dap通过血红素结合活性调节细胞色素P450蛋白功能的分子机制的阐明可能不仅适用于真菌界,还可应用于Dap蛋白对哺乳动物甾醇合成的调节。